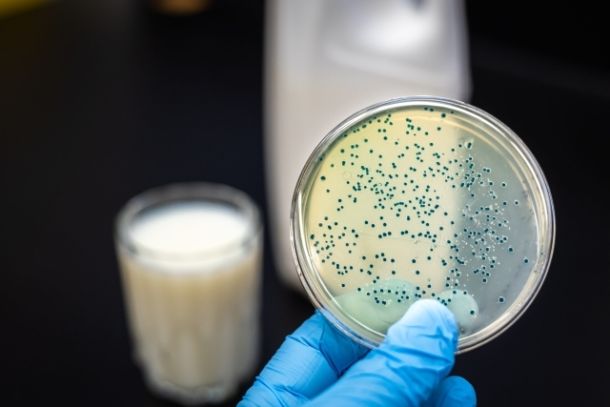

Courses & Programs to Support Your Health
Targeted Support
When You Need It Most
B Better Programs
- All
- #Digestive Relief
- #Energy – Stress & Hormones
- #Foundational Health
- #Full-Body Detox
- #Kitchen & Lifestyle
- #Mind-Body Support
- #Start Here (Beginner Friendly)

Sleep Optimization

10-Day Cleanse

Heartburn & Acid Reflux Resolution

Constipation Relief

SIBO/IBS Relief

Parasite Cleanse

Heavy Metal Detox
+Upcoming Program
You Don’t Have to Navigate Your Health Alone
Bite-Sized Learning,
Big Results
B Better Courses
- All
- #Digestive Relief
- #Energy – Stress & Hormones
- #Foundational Health
- #Full-Body Detox
- #Kitchen & Lifestyle
- #Mind-Body Support
- #Start Here (Beginner Friendly)

Beginner’s Health Roadmap

Read Food Labels

Blood Sugar Basics

Adrenal Support

Thyroid Support

Mineral Essentials

Fats & Inflammation

Gut Health Masterclass

Reading Your Labs
Mold & Mycotoxins

Holosonic Sound Therapy™
Join a Growing Community of Health Seekers Around the World
Finally — Solutions That Make You Feel Better
-
20+ Root-Cause Courses & Programs
-
Ask Experts: Get Answers in Under 24 Hours
-
100+ Symptom Tools, Guides & Protocols
-
Mobile App + Exclusive Community
-
No Contracts — Cancel Anytime
For your security, all orders are processed on a secured server.
Still Have Questions?
Courses are designed to educate and empower—you’ll find bite-sized video lessons you can explore at your own pace, covering everything from thyroid health to blood sugar, digestion, and more.
Programs are step-by-step action plans focused on specific symptoms like reflux, bloating, or fatigue—designed to help you take targeted action and feel better, faster.
Everyone’s journey is different. Some members feel a shift in just a few days—more energy, better digestion, clearer thinking—while others see deeper changes over time.
One member eliminated all her PMS symptoms within a month using the Beginner’s Health Roadmap. Another avoided a hysterectomy after her fibroids completely disappeared within a year.
What we promise is a clear path forward, ongoing support, and tools that actually work.
Yes—B Better isn’t just for people with symptoms. Many members join to stay healthy, prevent future issues, or make more informed choices for their families.
One member joined out of curiosity and ended up replacing dozens of everyday products in her home—helping her kids sleep better and get sick less often. Others have used the platform to deepen their knowledge during and after studying to become health coaches. And some, already working with clients, rely on B Better’s ready-made handouts and bite-sized video lessons to save time and better support their practice.
Whether you’re here to fix, prevent, or simply understand—there’s something for you.
Why B Better
Was Created
Founded by Bernadette Abraham—a holistic health specialist, functional medicine practitioner, author, and mom of four—B Better was born out of frustration: with dismissive doctors, conflicting advice, and how expensive it was to access real, personalized care.
After years of seeing clients struggle to find clear answers and affordable support, Bernadette created B Better to give people what was missing:
- A trusted place to learn, ask, and take action—without the overwhelm or the high cost.
Today, B Better is more than a platform. It’s a growing global community of people who are tired of guessing, ready to take charge, and want to feel better—naturally and confidently.
Bernadette Abraham
Real Stories. Life-Changing Results.
I’m SO happy—this month I didn’t get emotional, didn’t even notice my period, and still felt great working out. I got rid of all my PMS symptoms in just one month thanks to the Beginner’s Health Roadmap!
I couldn’t afford to see an MCAS specialist, but thanks to B Better’s diet guidelines, my symptoms didn’t just lessen—they were 100% gone after just one month! Words can’t express how thankful I am for this life-altering tool and the knowledge it gave me about my body.
Back in 2017–2019, my favorite foods would land me in hospitals, with colonoscopies and constant fear. Thanks to B Better, that feels like a different lifetime. The guidance and healing I received changed my life—not just physically, but emotionally. I finally trust myself and listen to my body. This isn’t just a membership—it’s a safe space I’m deeply grateful for every day.
Thank you for helping me save my uterus. My fibroids shrank from 7.6cm to 3.6cm—and my doctor confirmed I no longer need a hysterectomy. So grateful for this support over the years.
Your videos are wonderful—I’ve learned so much! Every topic helps me feel more confident caring for my family. And you have such a lovely way of speaking—it’s a joy to watch!
Thank you so much for your support. After implementing the suggestions from your arrhythmia handout, my father’s symptoms are completely gone. We’re so grateful!
You Deserve Answers. We’ll Help You Get Them.
Join 100+ members getting trusted, root-cause support—without the high cost or confusion.